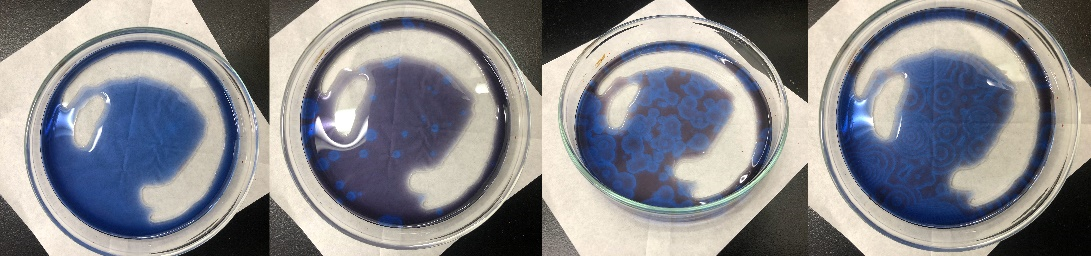

BZ反応
任元 疾鶴
1. 概要
化学反応はただ一方向に進行するものだ、というのが一般的な化学反応に対する認識かもしれません。しかしながら、化学反応の中には一定時間、周期的に反応を繰り返すものが存在します。これを振動反応と呼び、BZ反応(ベロウゾフ・ジャボチンスキー反応)はそうした化学反応の中で一番有名なものです。
2. 実験手順
2.1 試薬
- 臭素酸ナトリウム 2.5 g
- 臭化ナトリウム 0.25 g
- マロン酸 0.5 g
- 濃硫酸 1.7 mL
- 1,10-フェナントロリン一水和物 0.15 g
- 硫酸鉄(Ⅱ)七水和物 0.07 g
- 蒸留水 50 mL
- 50 mLビーカー 5個
- 駒込ピペット 6本
- 薬包紙 5枚
- 薬さじ 5個
- 精密ばかり 1個
- ガラス棒 5本
- メスシリンダー 1本
- シャーレ 1個
① 50 mLビーカーに蒸留水10 mLを計りとり、ここに臭素酸ナトリウム2.5 gを溶かす。これをA溶液とする。
② A溶液とは別の50 mLビーカーに蒸留水10 mLを計りとり、ここに臭化ナトリウム0.25 gを溶かす。これをB溶液とする。
③ A、B溶液とは別の50 mLビーカーに蒸留水10 mLを計りとり、ここにマロン酸0.5 gを溶かす。これをC溶液とする。
④ A、B、C溶液とは別の50 mLビーカーに蒸留水5 mLを計りとり、ここに濃硫酸1.7 mLを溶かす。溶解による発煙が収まったら、さらに蒸留水5 mLを計りとってこのビーカーに加える。これをD溶液とする。
※注意:濃硫酸の水への溶解は非常に大きな発熱を伴うため、濃硫酸に上から蒸留水を加えると突沸が起こり、液体が周囲に飛び散るため大変危険である。必ず予め計りとった5mlの蒸留水に、上から濃硫酸を少しずつ滴下するよう注意する。
⑤ 残った50 mLビーカーに蒸留水10 mLを計りとり、ここに1,10-フェナントロリン一水和物0.15 gと硫酸鉄(Ⅱ)七水和物0.07 gを溶かす。1,10-フェナントロリン一水和物は白色、硫酸鉄(Ⅱ)七水和物は青緑色の結晶であるが、両者を水中で混合すると溶液中のフェナントロリンが鉄(Ⅱ)イオンに配位してフェロインが生成するため、溶液はフェロインによって赤色に呈色する。これをE溶液とする。

図1:左から順に、A溶液、B溶液、C溶液、D溶液、E溶液。
※注意:臭素は有害なのでなるべく吸い込まないよう注意する。

図2:左から順に、D溶液の滴下から0、2、5、8、15分後のE溶液の様子。
図3:左から右へ、時間の経過に伴うシャーレ内の溶液の変化の様子。
3. 解説
BZ反応の反応機構は1972年にField、Körös、Noyesによって提案され、後にTysonによってまとめられました。まずは色の変化がなぜ見られたのかをざっくり解説しましょう。フェロインに含まれる鉄イオン(鉄のフェナントロリン錯体)は、酸化数が+2のときは赤色、+3のときは青色を示します。BZ反応が起こっている最中、この鉄イオンの酸化と還元が繰り返し起こっており、色の変化が観察されたんですね。
それではここから、丁寧に各反応を追っていくことで、本題の「なぜ酸化と還元を繰り返すのか?」という話に移っていきましょう。便宜上、この反応の機構を過程Aと過程Bに分けて考えます。
過程A
まず、A溶液とB溶液にはそれぞれ臭素酸ナトリウムと臭化ナトリウムが溶解していました。これらは水中では電離して、それぞれ臭素酸イオン、臭化物イオンとして溶液中に存在します。(ナトリウムイオンは反応に大きくかかわらないので省略します。) 臭素酸イオンは比較的速く臭化物イオンを酸化します。これが過程Aの第一段階で、以下の反応が起きます。
\begin{align}
\ce{BrO_3^- + Br^- + 2H^+} &\rightarrow \ce{HBrO_2 + HOBr} \\
\ce{HBrO_2 + Br^- + H^+} &\rightarrow \ce{2HOBr} \\
\ce{HOBr + Br^- + H^+} &\rightarrow \ce{Br^2 + H_2O}
\end{align}
これらの反応の正味の変化は(式1) + (式2) + 3(式3)で求まり、このようになります。
\begin{align}
\ce{HBrO_3 + 5Br^- + 5H^+} \rightarrow \ce{3Br_2 + 3H_2O} \\
\end{align}
上の一連の反応は臭化物イオンによる臭素酸イオンの還元をしているとみることもできます。
この時生成した臭素分子はマロン酸と反応し、ブロモマロン酸と臭化水素酸を生成します。これが過程Aの第二段階です。マロン酸はジカルボン酸のままでは臭素分子と反応しませんが、ケト-エノール互変異性によってできたエノール形のものと非常に速く反応します。
\begin{align}
\ce{HOOC-CH2-COOH} &\rightleftharpoons \ce{HO(HO)C=CH-COOH} \\
\ce{Br2 + HO(HO)C=CH-COOH} &\rightarrow \ce{HO(Br)C=CH-COOH + Br- + H+}
\end{align}
式6で臭素分子がエノールと反応し、エノールの濃度が減少するにしたがって式5の平衡は右に偏ります。これに伴ってジカルボン酸はゆっくりとエノールを生成します。よって、臭素が消費される速度はエノール化反応の速度で決定されます。
式4が示すように、過程Aでは5個の臭化物イオンを消費して3個の臭素分子を作ります。一方、式5、式6のマロン酸との反応を通して1個の臭素分子が1個の臭化物イオンに戻ります。したがって、これらの反応によって臭化物イオンの濃度が減少していきます。臭化物イオンの濃度が比較的高いと、式2で臭化物イオンが生成してすぐに\(\ce{HBrO2}\)が消費されます。しかし濃度が低くなるとこの消費が非常に遅くなり、過程Aの速度が無視できるようになるため、過程Bにとって代わられます。
過程B
\begin{align}
\ce{2H+ + BrO3- + HBrO2} &\rightarrow \ce{HBrO2+ + BrO2. + H2O} \\
\ce{BrO2. + H+} &\rightarrow \ce{HBrO2+} \\
\ce{Fe(phen)3^2+ + HBrO2+} &\rightarrow \ce{Fe(phen)3^3+ + HBrO2} \\
\ce{2HBrO2} &\rightarrow \ce{HOBr + HBrO3} \\
\ce{2HOBr} &\rightarrow \ce{HBrO2 + Br- + H+} \\
\ce{HOBr + Br- + H+} &\rightarrow \ce{Br2 + H2O}
\end{align}
式1で生成する\(\ce{HBrO2}\)は式7で\(\ce{BrO3-}\)と反応し、\(\ce{BrO2.}\)ラジカルを生成します。このラジカルは式8、式9の通り、\(\ce{H+}\)と反応して\(\ce{HBrO2^+}\)となり、溶液Dに由来する\(\ce{Fe(phen)3^2+}\)と反応します。この3つの反応の正味の変化は、(式7) + (式8) + 2(式9)より、以下のようになります。
\begin{align}
\ce{3H+ + BrO3^- + Fe(phen)3^2+ + HBrO2} \rightarrow \ce{H2O + Fe(phen)3^3+ + 2HBrO2}
\end{align}
この反応は\(\ce{HBrO2}\)が自触媒的に生成することを示しています。この自触媒的道筋が、振動反応で重要な「フィードバックループ」を与えます。「フィードバックループ」とは、以下のようにある段階の速度がその後の段階で生成する物質の影響を受ける反応機構を意味します。
\begin{align}
\ce{A} &\rightarrow \ce{X} \tag{a}\\
\ce{X + Y} &\rightarrow \ce{2Y} \tag{b}\\
\ce{Y} &\rightarrow \ce{Q} \tag{c}
\end{align}
この反応機構は1910年にAlfred Lotkaによって提案されたものです。これらの初濃度、反応速度定数を適当な値に設定すると、以下のグラフのように中間体X、Yの濃度が振動します。この反応機構では、式bが自触媒的になっています。

式11と式12は次亜臭素酸の亜臭素酸と臭素分子への不均化を表しています。この2つの反応の正味の変化は、(式11) + (式12) より、以下のようになります。 \begin{align} \ce{3HOBr} &\rightarrow \ce{HBrO2 + Br2 + H2O} \end{align} この反応式は臭素分子が過程Bでどのように生成するかを示しています。次亜臭素酸も溶液中で有機ラジカルと反応し(下記参照)、これは不均化で生成する臭素分子の量を制約します。
過程Bで起こる正味の変化は5(式7) + 5(式8) + 10(式9) + 3(式10) + (式11) + (式12)により得られます。
\begin{align} \ce{12H+ + 2BrO3- + 5Fe(phen)3^2+} &\rightarrow \ce{5H2O + 5Fe(phen)3^3+ + Br2 + H2O} \end{align} 式15からの\(\ce{Fe(phen)3^3+}\)は有機化学種により還元されます。還元剤の1つは式6で生成するブロモマロン酸です。 \begin{align} \ce{Fe(phen)3^3+ + CHBr(COOH)2} &\rightarrow \ce{Fe(phen)3^2+ + H+ + .CBr(COOH)2} \end{align} 式16で表される過程の有機ラジカル中間体も\(\ce{HOBr}\)を\(\ce{Br-}\)に還元します。そのため、これは式3を通しては反応できません。\(\ce{HOBr}\)と\(\ce{Fe(phen)3^3+}\)が十分生成すると、\(\ce{Br-}\)が非常に速く生成するので、式2の速度が式7の速度を大きく上回り、式4で表されるように反応は再び過程Aに従います。
過程Aと過程Bは亜臭素酸に対する臭化物イオンと臭素酸イオンの競合を生じます。臭化物イオンの濃度が高いとほぼすべての亜臭素酸がそれと反応し、過程Aをたどります。この過程の間、臭化物イオンは減少を続け、臭化物イオンは亜臭素酸を求める競争に負け、過程Bに取って代わられます。この過程Bは臭化物イオンを生成し、臭化物イオンの濃度が高くなってまた過程Aに戻ります。これらの繰り返しが振動を生み出すのです。

マロン酸は臭素分子により臭素化されます。この臭素化されたマロン酸を\(\ce{BrMA}\)と表現します。この臭素分子は2種類の過程A、Bにより生成されます。どちらの過程が支配的であるかはその時の臭化物イオンの濃度によります。過程Aは臭素酸イオンと臭化物イオンが消費されて臭素分子ができる過程で、過程Bは、臭素酸イオンを消費して\(\ce{Fe(phen)3^2+}\)を\(\ce{Fe(phen)3^3+}\)に酸化する過程です。\(\ce{Fe(phen)3^3+}\)は臭化物イオンを生成する反応に参加します。臭化物イオンの濃度が臨界レベルを超えると過程A、濃度が低いと過程Bが支配的となります。過程Aが臭化物イオンを消費すると、臭化物イオンの濃度が減少して過程Bが働くようになり、過程Bは間接的に臭化物イオンを放出して反応を過程Aによる支配に戻します。このようにして振動が繰り返されるのですね。
4. 最後に
随分と長い解説になってしまいました…振動反応は複雑なので仕方ないですね。振動反応は見た目の美しさもさながら、複雑な反応機構を通して現れる調和のとれた現象が魅力的だと思います。振動反応はBZ反応だけではなくBR反応と呼ばれるものもあります。こちらの反応も魅力的ですので、ぜひ検索してみてください。
5. 参考文献・サイト
- Bassam.Z.Shakhashiri 著. 池本勲 訳.「教師のための化学実験 ケミカルデモンストレーション6 振動反応と時計反応」(解説中の図は前者がここから引用、後者はここの図を参考にして作成しました)
- 山田暢司. らくらく化学実験 振動反応に感動!http://rakuchem.com/bz.html. 閲覧日:2018年11月16日
- 阿部二朗. 「夢・わくわく化学展2001」実験dvd時間と空間のリズム反応. http://www.chemistry.or.jp/edu/magic-dvd/chemical_05rythm.html. 閲覧日:2020年11月19日
- 「ferroin型BZ反応のRovinsky,Zhabotinskyモデルの特性について」http://www.chem.scphys.kyoto-u.ac.jp/nonnonWWW/b8/05f/nakamura/nakamura.pdf. 閲覧日:2020年11月19日
- >西村 美紀枝 ほか2名. 「サイエンスアゴラに於ける振動反応演示の工夫」 https://ci.nii.ac.jp/naid/110009942900. 閲覧日:2020年11月19日
